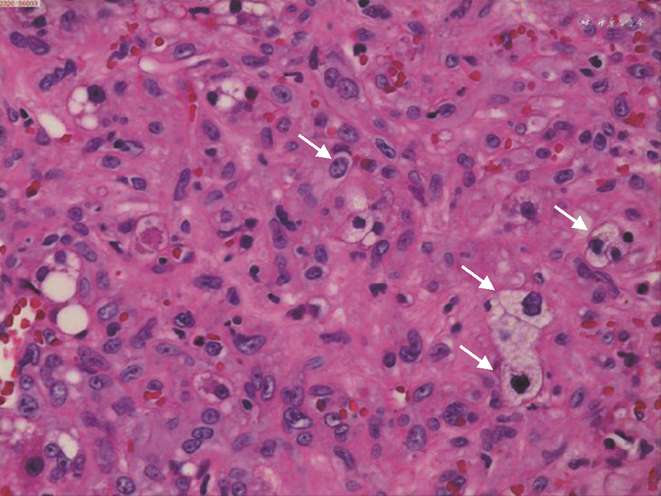

肝脏上皮样血管内皮瘤是一种罕见的低、中度恶性肿瘤,由于其多变的临床特征及不典型的影像学表现,患者首次就诊的误诊率高达85%。目前诊断金标准主要依靠病理及免疫组化诊断,治疗上主张手术切除肿瘤和肝移植,但术后防止肿瘤复发和(或)转移才是对该疾病系统性治疗的长久之计。
版权归中华医学会所有。
未经授权,不得转载、摘编本刊文章,不得使用本刊的版式设计。
除非特别声明,本刊刊出的所有文章不代表中华医学会和本刊编委会的观点。
患者女,1963年3月出生,既往体健,曾接种过乙肝疫苗,2011年10月31日因“体检发现肝脏占位10余天”入院。入院时患者无任何不适症状,既往无手术史,无长期药物使用史,无烟酒嗜好,无放射性物质、化学物品等接触史。入院查体:神志清,精神可,营养状态良好,皮肤巩膜未见黄染,无出血点,无肝掌、蜘蛛痣;心肺听诊无殊;全身浅表淋巴结未触及,全腹平软,无压痛、反跳痛,未触及腹部包块,肝脾肋下未及;肝区叩击痛(-),Murphy征(-),移动性浊音(-),肠鸣音4次/min。实验室检查:肝功能正常,乙肝系列检查HBsAb92.83↑、HBcAb0.008↓,其余指标正常;肿瘤标记物CEA、AFP、CAl99、CAl25等均在正常范围内。影像学检查:肝脏B超(本院2011-10-20)显示:右肝及大小约3.0 cm×3.0 cm×3.6 cm实质偏低回声结节区,边界可及;胆脏B超:大小形态正常,壁上及约0.6 cm偏强回声结节,向囊内隆起,胆总管未见明显扩张。提示:右肝实质低回声团块,建议进一步检查;胆囊息肉。全腹部CT平扫+增强(本院2011.10.21)显示:肝脏各叶大小比例正常,肝右叶前上段见一团状低密度影,大小约26 mm×24 mm,边缘略模糊;增强后病灶边缘略强化,延迟后病灶有缩小,肝内外胆管不扩张。上腹部MR平扫+增强(本院2011-10-25)显示:肝脏各叶大小比例正常,肝右叶前上段见一团块异常信号灶,大小约29 mm×31 mm,T1低信号,T2高信号,DWI稍高信号;增强早期病灶边缘强化,延迟后病灶有明显缩小,肝内外胆管不扩张。提示:肝右叶前上段占位,不典型的血管瘤可能,胆管细胞癌不能完全排除,请结合临床建议进一步检查。排除手术禁忌后于2011年11月2日在全身麻醉下行右肝部分切除术,术中见肿块位于右肝第Ⅶ段,大小2.0 cm×3.0 cm、色灰白、质地硬,累及肝脏表面,决定行右肝部分切除术。术后常规病理(本院2011-11-09)示:(右肝)上皮样血管内皮瘤(低-中度恶性)(图1)。免疫组化:本院:Vim(+++)、CD34(+++)、CD31(++);HMB-45、S-100、CK7、CK19、CK8/18均(-);浙江大学医学院第一附属医院:CK(+/-)、CK19(-)、Hep(-)、Ki-67(5%+)、CD34、CD31、Fli-1均(+++)。


患者第1次出院后未进行药物治疗,定期在我院或浙江大学医学院第一附属医院复查肝胆B超和(或)上腹部CT,均未发现明显异常。上腹部CT平扫+增强(2018-04-19)影像所见:肝右叶部分切除术后,肝左叶低密度结节影,范围约34 mm×52 mm,边界清;平扫CT值约32 HU,延迟期边缘呈结节样轻度强化,病灶有缩小(图2)。影像诊断及建议:肝右叶部分切除术后;肝左叶占位,血管内皮瘤可能性大,其他病变不除外,请结合临床必要时进一步检查。患者于2018年5月9日第2次入院,实验室检查示:肝功能正常,乙肝系列检查HBsAb48.180↑、HBcAb0.010↓,其余指标正常;肿瘤标记物中CA724 13.94↑,其余肿瘤标记物CEA、AFP、CAl99、CAl25等均在正常范围内。排除手术禁忌后于2018年5月12日行腹腔镜下左肝部分切除术,术中用超声刀游离左肝叶周围组织,用腹腔镜下直线切割闭合器分离离断左肝外叶。术后病理(本院2018-05-16)示:(左肝)上皮样血管内皮瘤(直径6.5 cm)(图3)。免疫组化B片:AFP(-)、CD31(+++)、CD34(+++)、CD19(-)、CK7(-)、CK8/18(-)、D2-40(灶+)、Vim(++)。免疫组化诊断结果:B片:AFP(-)、CD31(+++)、CD34(+++)、CD19(-)、CK7(-)、CK8/18(-)、D2-40(灶+)、Vim(++)。




患者第2次手术后同样未进行药物治疗,仅进行定期复查。全腹部CT平扫+增强(本院2020-11-06)示:尾状叶类圆21 mm×23 mm稍低密度伴轻度强化,肝裂旁稍肿大淋巴结(图4);肝右叶部分切除术后,肝左叶占位术后,请结合临床。肝尾状叶占位灶,转移瘤待排,建议进一步检查。实验室检查(本院2020-11-05)示:肝功能正常,乙肝系列检查HBsAb86.800↑、HBcAb0.010↓,其余指标正常;肿瘤标记物CEA、AFP、CAl99、CAl25、CAl53、CA724等在正常范围内。排除禁忌后于2020年11月7日行复杂肝癌切除术,术中充分暴露肝尾状叶,用超声刀、氩气刀切除肝尾状叶并予以残端止血。切除的尾状叶送病理科行术中冰冻快切病理检查,诊断为(肝脏)上皮样血管内皮瘤。病理组织学诊断结果(本院2020-11-13):(1)(肝脏)上皮样血管内皮瘤(肿块大小2.5 cm×2.0 cm;图5),伴见脉管内瘤栓,切缘阴性,送检(第7、8、9、1、3、12组)3/13个淋巴结见肿瘤细胞转移;(2)部分肝组织;(3)注:该肿瘤组织免疫组化提示CK8/18及AFP阳性,提示该肿瘤存在向上皮成分分化。免疫组化诊断结果:E片:CD31(+++)、CD34(+++)、FLI-1(+++)、CK8/18(+++)、CK19(-)。H片:AFP(+)、CD31(+++)、CD34(+++)、CK19(-)、FLI-1(++)、CK8/18(+)、D2-40(-)、Ki-67(+)15%、Vim(+++)、EMA(-)。

肝上皮样血管内皮瘤(hepatic epithelioid hemangioendothelioma,HEHE)是一种罕见的低-中度恶性肿瘤[1],发病率约为百万分之1-2例[2],男女发病比例约为2∶3[3]。由于其极低的发病率,即使像浙江大学医学院第一附属医院肝胆胰外科这样大规模的诊疗中心,在2011年1月至2017年12月的7年中也只有12例HEHE(9例女性、3例男性)[4],故目前国际上尚无诊疗指南或专家共识。郑树森院士团队对HEHE初步治疗方案流程建议:(1)病理诊断明确的HEHE首先进行1~3个月的观察,若病情稳定则继续定期观察;(2)若病情进展则需进行外科手术治疗;(3)单发结节可选择肝部分切除术或是射频消融术;(4)弥散性肝累及则选择肝移植术[4]。
Mehrabi等[3]对434例HEHE患者的回顾性研究中治疗方式的选择依次为肝移植、定期观察、化疗或放疗、肝切除,其中肝切除术后1、5年生存率呈现最大值,其次为肝移植、化疗或放疗,最后为定期观察。从表1中可见积极主动的治疗优于消极被动的定期观察,外科手术治疗优于放、化疗。

肝上皮样血管内皮瘤不同治疗方式的使用率和生存率(%)
肝上皮样血管内皮瘤不同治疗方式的使用率和生存率(%)
| 治疗方式 | 使用率 | 1年生存率 | 5年生存率 |
|---|---|---|---|
| 肝移植 | 44.8 | 96.0 | 54.5 |
| 定期观察 | 24.8 | 39.3 | 4.5 |
| 化疗或放疗 | 21.0 | 73.3 | 30.0 |
| 肝切除术 | 9.4 | 100 | 75.0 |
对于本例患者,第1次手术治疗后考虑到肿瘤转移或复发的可能性所以从未让患者停止复查,但未采取积极措施去预防,即使是第2次手术后依旧未采取药物治疗,这是笔者团队应该深刻反省的。此外,该患者第1次手术后6.5年发生了第1次复发,第2次手术后2.5年发生了第2次复发,而且二次复发的肿瘤存在向上皮成分分化。复发时间的大幅度缩短与肿瘤分化倾向于上皮成分是否为手术本身原因造成的,还有待进一步研究。患者第3次手术后的治疗重点在于通过药物治疗预防肿瘤复发,根据文献报道对HEHE有效的药物有免疫调节药贝伐单抗[5]、化疗药物索拉菲尼[6]、血管生成抑制剂帕唑帕尼[7]及干扰素α-2b,综合考虑上述药物的药代动力学、价格和不良反应等因素,我们团队采取重组人干扰素α-2b注射液(凯因益生)3 000 000 IU皮下注射qod治疗,预计使用1.5年,期间根据其复查及药物副作用的情况调整药物使用剂量、频率及周期。
关于干扰素治疗HEHE,有以下2篇报道。Kayler等[8]曾报道过1例HEHE合并盆腔多发转移的21岁女性患者,该患者在接受肝移植手术后使用干扰素α-2b治疗,其每日接受3 000 000 IU剂量皮下干扰素α-2b治疗,同时继续免疫抑制剂治疗(环孢素和泼尼松)。惊奇的是患者接受干扰素治疗7 d后盆腔疼痛奇迹般地完全缓解,而且患者对干扰素耐受性良好;但在第4个月,经活检证实患者发生了轻度移植物排斥反应。作者分析干扰素治疗肝移植术后转移性上皮样血管内皮瘤可能导致症状减轻和肿瘤减少,但也可能导致移植物排斥反应;干扰素治疗最有利的时间可能是在移植前,以潜在地减缓肿瘤生长和防止转移。Galvão等[9]对1例38岁患有HEHE(分别位于肝Ⅳ段9 mm、Ⅵ段14 mm和Ⅶ段35 mm的3个结节)的白种女性患者围手术期使用干扰素α-2b治疗,治疗方案包括肝Ⅵ、Ⅶ段和Ⅳb亚段切除前9周和术后1周的每日皮下注射3 000 000 IU干扰素α-2b。患者在术后早期出现自限性胆瘘,术后3年内保持无瘤健康生存状态。
至于干扰素α-2b的作用机制,曹斌等[10]通过动物实验证实了其抑制肝癌细胞生长,一方面是通过下调环氧合酶-2(cyclooxygenase-2,COX-2)的表达,诱导肿瘤细胞凋亡;另一方面是通过下调血管内皮生长因子(vascular endothelial growth factor,VEGF)的表达,抑制肿瘤血管的生成,进而抑制肿瘤的生长;而COX-2的表达可能调控或影响了VEGF的表达。此外,Telli等[11]通过对4例HEHE患者的经验性治疗也证实了抗VEGF治疗的有效性,使用针对VEGF-VEGFR通路的药物治疗这种血管来源且伴随VEGF高表达的肿瘤论据充分。
对于该罕见病目前鲜少有学者通过动物实验论证其作用机制,亦无大样本量的临床药物试验结果;仅有全国各地的患者及家属自发组建的战友群中对干扰素α-2b的使用成果分享,普遍反映收益显著。截止目前,本例患者在使用干扰素α-2b后出现了消化道不适、轻度自限性皮疹、白细胞减低等副作用,予以质子泵抑制剂、升白细胞等对症支持治疗后症状缓解,对其进行有效的心理疏导后患者愿意克服困难继续使用干扰素。
总之,笔者主张应积极外科手术切除肿瘤,然后配合规律的干扰素治疗以预防肿瘤转移和复发,根据定期复查结果调整干扰素使用频次。
高帆, 章鲁艇, 徐鹏远. 多次复发的肝脏上皮样血管内皮瘤1例[J]. 中华转移性肿瘤杂志, 2023, 6(1): 68-71. DOI: 10.3760/cma.j.cn101548-20210227-00029.
利益冲突所有作者声明无利益冲突





















